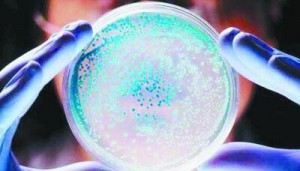

微信投票宝宝大赛现在可以说是层出不穷,各种萌宝,萌娃的宝宝大赛每天都举办着,而那些宝宝的家长也非常喜欢给自己家的宝宝报名参加这样的投票活动,而家长们给宝宝报名完事之后,肯定就开始天天群发信息拉票了,所以现在很多人都非常烦感这样的宝宝大赛拉票,那么家长们其实也感觉的到,所以现在越来越多的家长不在选择通过拉票提升票数了,转而是选择通过刷票的方式来进行提升票数,那么今天小编要给大家说的就是如何通过刷票给宝宝提升票数。 1、宝宝大赛想要通过刷
最近有没有很有兴趣了解一下cv投票公司刷票的问题?这家简历投票公司刷票。目前我们在百度上搜索一些与微信投票相关的信息,这个cv投票公司刷票。很多人对这家公司很好奇。搜索微信投票时为什么会出现这家公司?其实这种情况是因为公司刷了一些百度下拉框索引,然后才会出现这种情况。
1.但是,我们不太明白cv投票公司刷票是否可靠,所以当朋友问我们这样的问题时,我们真的不是很容易介绍给大家,因为我们真的不太了解,所以没有办法告诉为什么会这样。

2.不过目前如果你想通过投票刷公司增加票数,我们可以推荐给你,感兴趣的朋友可以参考专为刷公司撰写的文章《渔人微信手动投票拉票团队,微信投票行业领袖》。

转载请注明:微信点赞 » 投票小程序微信怎么弄,Cv投票公司刷票
